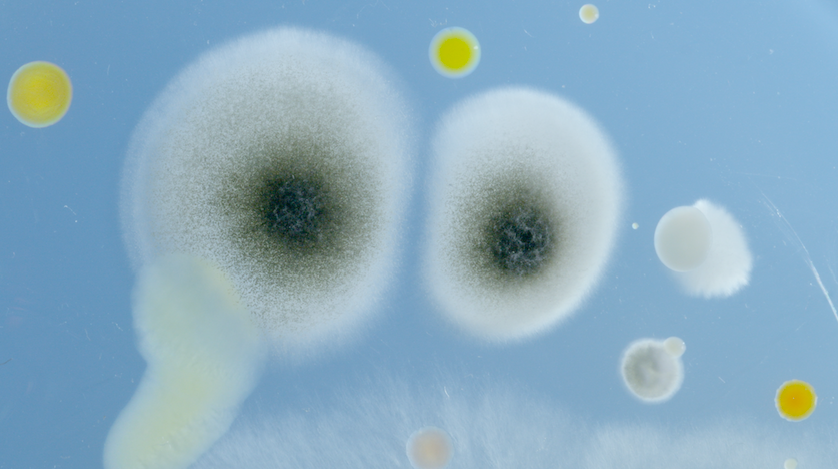

เปิดเรื่องราวของสิ่งมีชีวิตขนาดเล็ก ที่เมื่อเราหายใจเข้าไปแล้ว กระทบกับระบบในร่างกายอย่างแน่นอน ใน "Microorganisms: The Air We Breathe"
เรียกได้ว่าเป็นอีกหนึ่งสารคดีที่ทันยุค ทันสมัยแบบขั้นสุดสำหรับ "Microorganisms: The Air We Breathe" โดยตลอดการติดตามจะพาทุกคนไปพบกับสารคดีวิทยาศาสตร์ที่จะพาคุณไปส่องเหล่าไอ่ต้าวไวรัสและเชื้อแบคทีเรีย ที่มันอยู่รอบตัวเรา ถึงแม้เราจะมองไม่เห็นพวกมันก็ตาม เรียกว่าตอนนี้เชื้อโรคต่างๆ สามารถอยู่ในอากาศและนับวันจะยิ่งทวีความรุนแรงมากขึ้นเรื่อยๆ ยกตัวอย่างข่าวดังในประเทศไทยที่กำลังเป็นที่พูดถึงในตอนนี้อย่าง "นกพิราบ" ที่มีหญิงป่วยเป็นปอดอักเสบโดยจากการตรวจของแพทย์แล้วพบว่ามีการเกี่ยวโยงไปกับที่เธอให้อาหารนกเป็นประจำ เรียกว่าเป็นอีกหนึ่งเคสที่ตกติดตามอย่างใกล้ชิด รวมไปถึงคนที่ชื่นชอบในเรื่องของสัตว์เลี้ยง หรือขนของสัตว์ที่จะต้องระมัดระวังเป็นพิเศษ


โดยนอกจากแบคทีเรียแล้วก็ยังมี ฝุ่นละออง เกสรดอกไม้ สิ่งเหล่านี้เล็กจนไม่สามารถมองเห็นด้วยตาเปล่า แต่สิ่งเล็กๆนี่แหละ ที่ส่งผลกระทบต่อการดำเนินชีวิตของสิ่งมีชีวิตบนโลกนี้ไม่ใช่น้อย เรียกว่าตลอดการรับชมจะได้เห็นถึงเรื่องราว พร้อมทั้งสาระความรู้ดีๆ จากเรื่องของสิ่งเล็กๆ ที่เรามองไม่เห็นตลอดจนถึงเรื่องราวของพวกมันว่าจะเป็นผลกระทบ รวมไปถึงส่งผลกับชีวิตของมนุษย์อย่างไร เรียกว่าสารคดีชุดนี้นอกจากจะพาเราไปสำรวจเรื่องราวของสิ่งเล็กๆ เหล่านั้นแล้ว ยังเห็นทั้งข้อมูลดีๆ พร้อมแนวทางการระมัดระวังตลอดทั้งเรื่องอีกด้วย รับประกันว่าใครที่ได้ติดตามเรื่องราวของสารดีชุดนี้จะได้รับความรู้ พร้อมเปิดโลกสิ่งเล็กๆ อย่างแบคทีเรียที่คุณอาจจะยังไม่เคยพบมาก่อนได้แน่นอน

ถึงตอนนี้เชื่อว่าหลายคนคงอยากที่จะติดตามเรื่องราว พร้อมทั้งเปิดการสำรวจทางวิทยาศาสตร์นี้จะพาเราไปสู่ใจกลางโลกที่ยังไม่ค่อยมีใครเข้าใจ พร้อมเผยให้เห็นถึงความหลากหลายและความเปราะบางของอากาศที่เราหายใจเข้าไป เรียกว่าได้ความรู้ พร้อมทั้งสาระดีๆ แบบจัดเต็มอย่างแน่นอน สามารถติดตามเรื่องราวทั้งหมดได้ในสารคดี "Microorganisms: The Air We Breathe" วันนี้เวลา 22.00 น. ทาง True Explore Sci (561) ที่ทรูวิชั่นส์เท่านั้น #truevisions #documentary #air #breathe #ไวรัส #ฝุ่น #ป่วย #แบคทีเรีย #สารคดีมีที่ทรู #สารคดีต้องดู #นก #นกพิราบ

truevisions
อัปเดตข่าวล่าสุดก่อนใคร :
Website : www.truevisions.co.th
Facebook : Truevisions
Twitter : @TrueVisions
Line : @Truevisions
Youtube official : Truevisionsofficial
Instagram : Truevisionsofficial